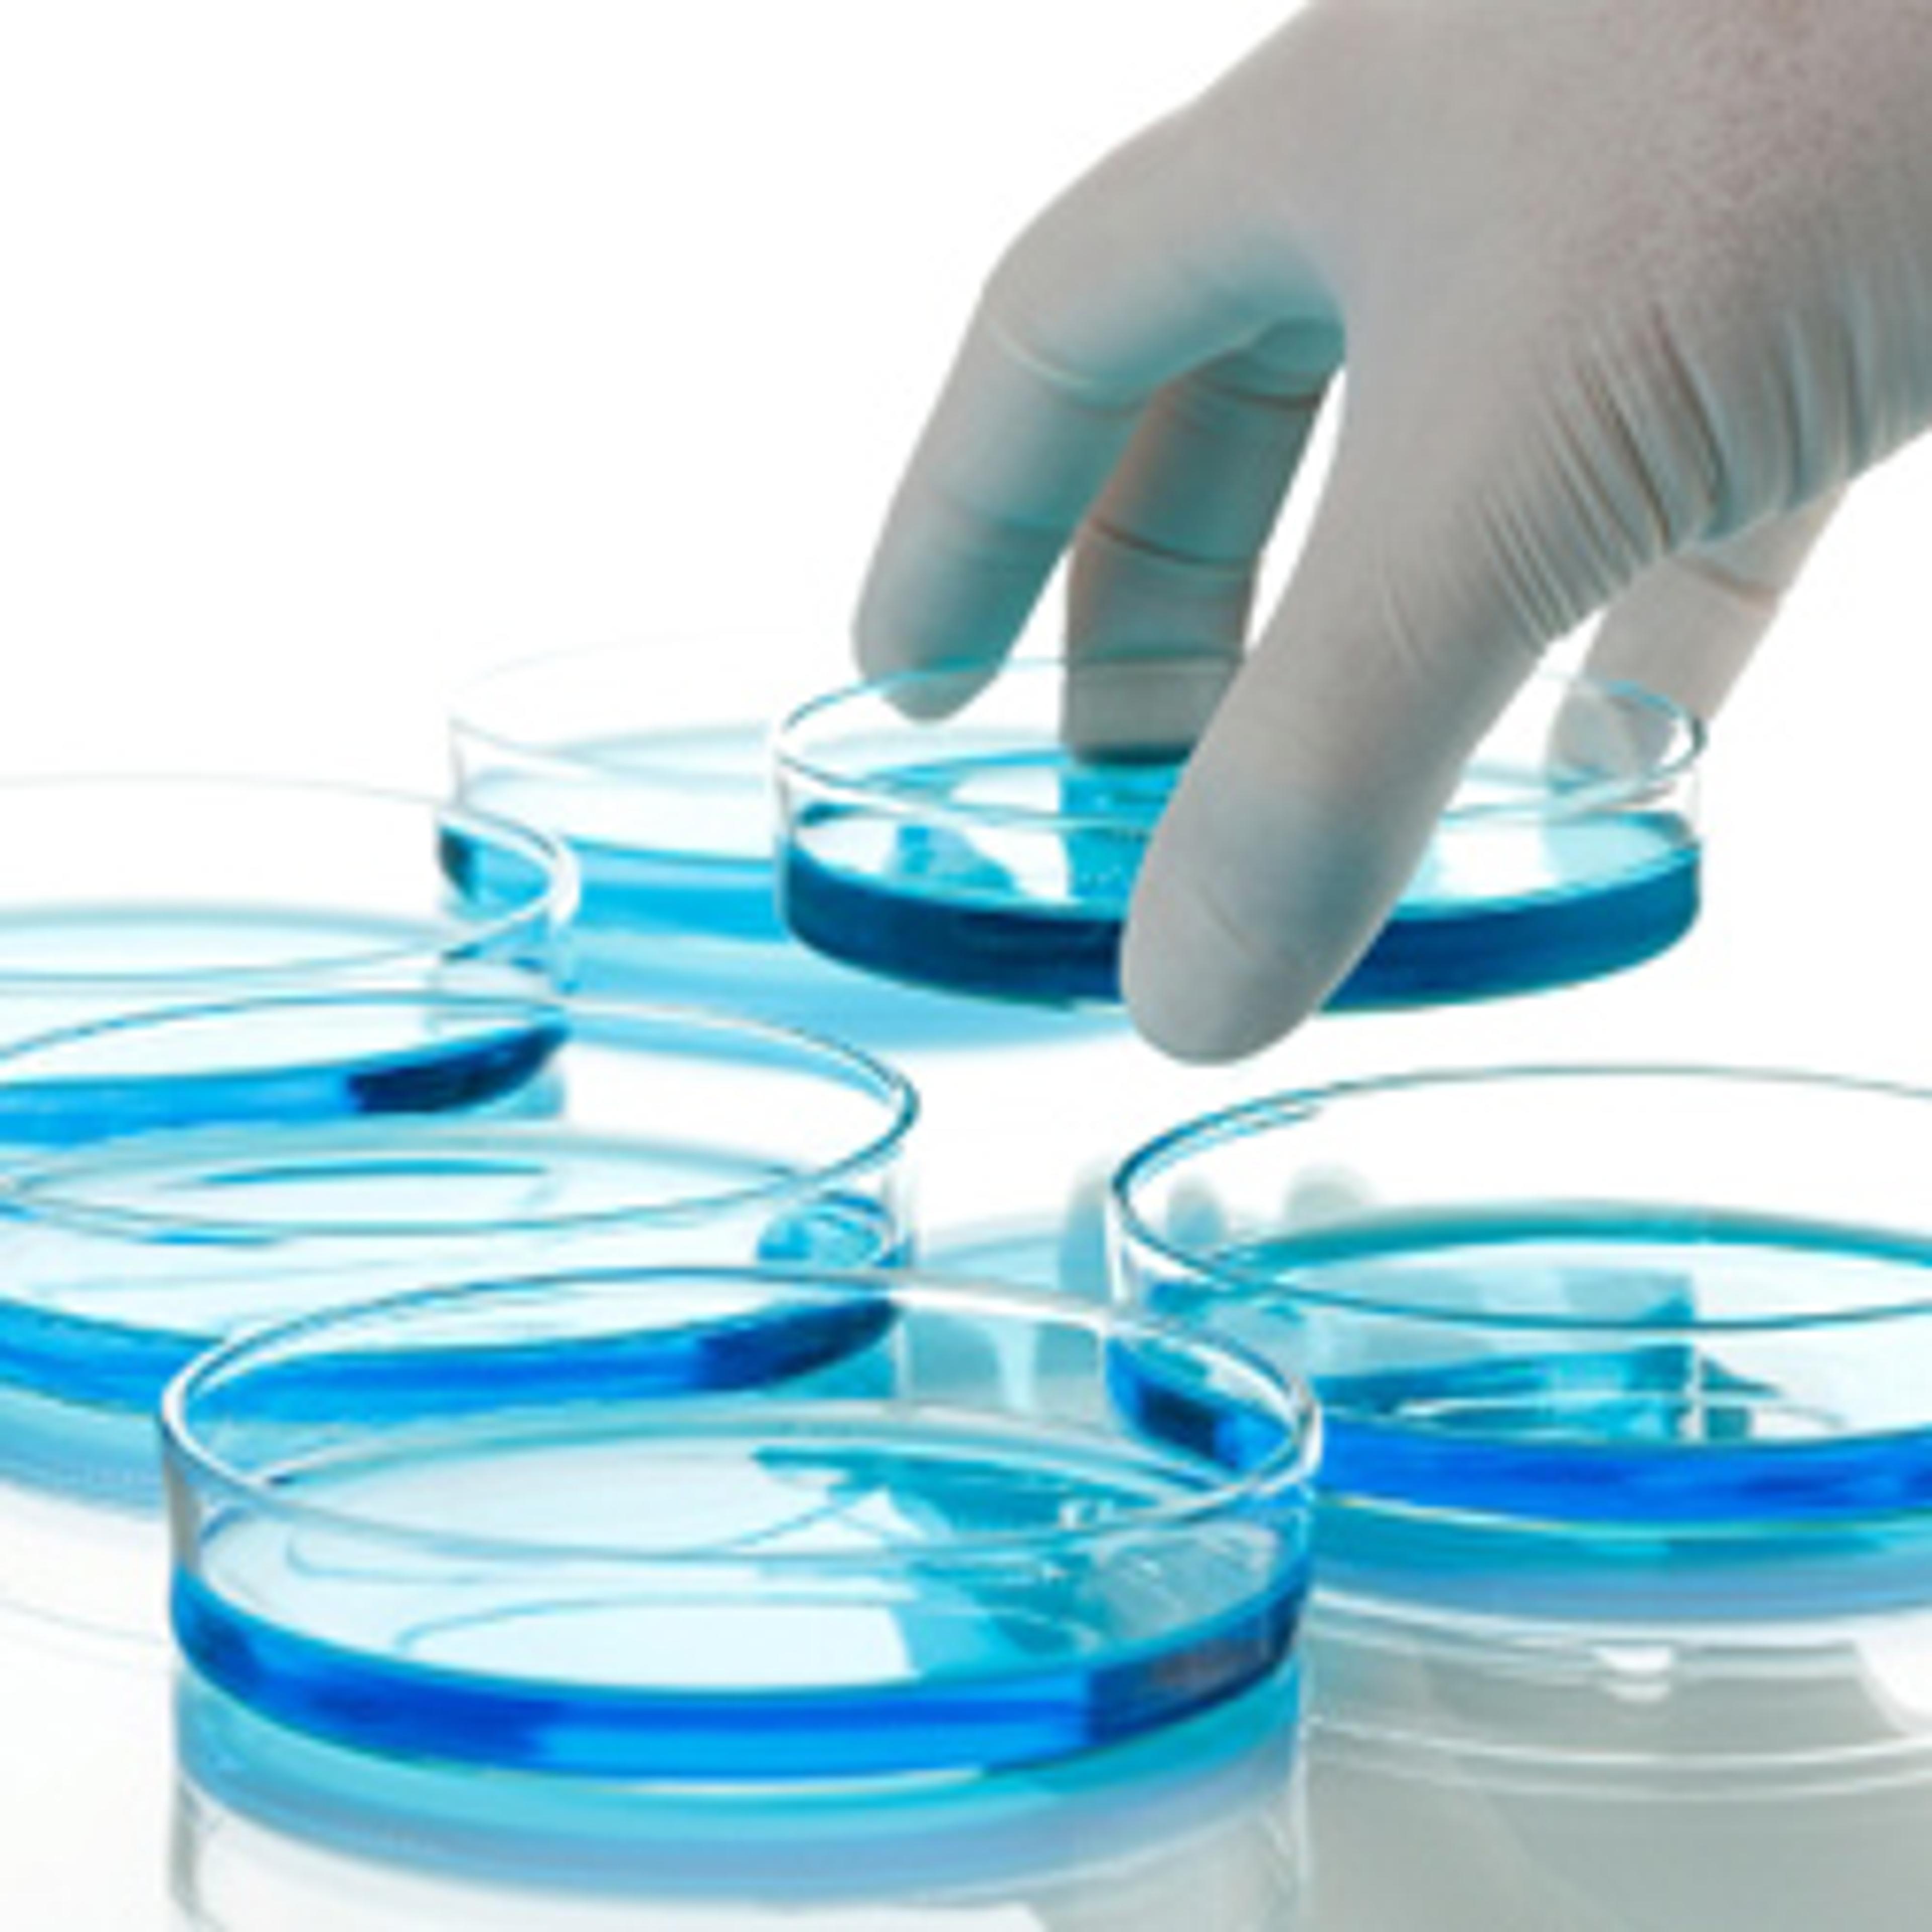

News & Articles
25
Selected Filters:
Product News
Quotient Upgrade to the Latest LabLogic Software
Industry News
Analytik Jena Present at ARABLAB 2012
Product News
The Future of Laboratory Sample Processing?
Product News
Time Savings via New LIMS Module
Product News
Labvantage 6 New and Improved LIMS
Product News
Flexible Multi-Groups LIMS Solution
Product News
New Fully-Integrated LIMS
Product News